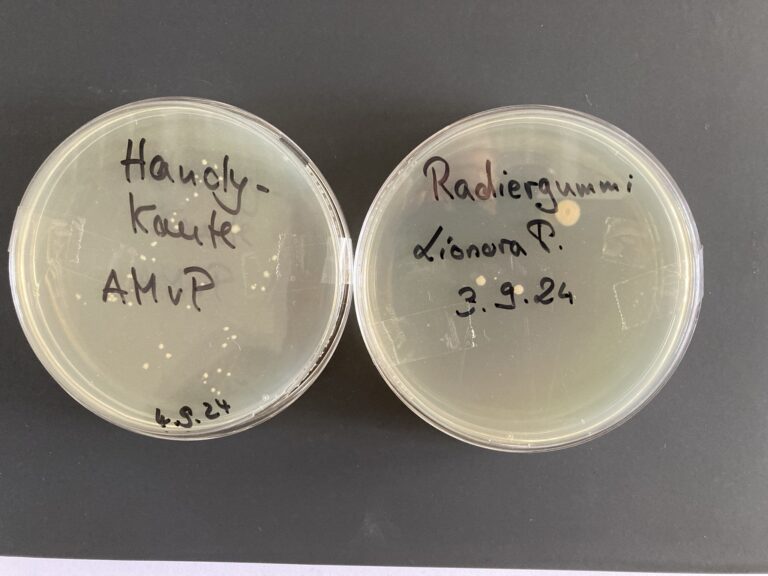

In unserem Projekt zum Thema Hygiene haben wir uns intensiv mit Bakterien und deren Nachweis beschäftigt. Dabei haben wir nicht nur gelernt, dass Mikroorganismen in unserer unmittelbaren Umwelt allgegenwärtig sind, sondern auch, dass sie sich auf unseren Händen und anderen Oberflächen befinden.
Im Rahmen unserer Untersuchungen haben wir verschiedene Gegenstände aus unserem Schulalltag auf das Vorhandensein von Mikroorganismen getestet. Auch die Luftqualität in unserem Unterrichtsraum sowie im Flur wurde analysiert. Die Ergebnisse waren aufschlussreich: Bakterien sind überall um uns herum – und das ist ganz normal! Es gibt keinen Grund zur Besorgnis, denn viele dieser Mikroben sind harmlos oder sogar nützlich.
Ein wichtiger Bestandteil unseres Projekts war das Erlernen der richtigen Handhygiene. Wir haben herausgefunden, wie man sich korrekt die Hände wäscht und welche Rolle Desinfektionsmittel dabei spielen. Besonders wichtig ist es, Desinfektionsmittel mindestens 30 Sekunden einwirken zu lassen, um effektiv zu sein.
Gemeinsam haben wir einen Hygieneplan erarbeitet, der uns helfen soll, während der nächsten Erkältungswelle gesund zu bleiben. Dieser Plan enthält wichtige Hinweise, was wir innerhalb der Schule beachten sollten – von der regelmäßigen Handdesinfektion bis hin zu Verhaltensregeln im Klassenraum.
Ein besonders anschauliches Experiment war die Untersuchung von Ablatschplatten mit Bakterienkolonien. Diese visuelle Darstellung hat uns eindrucksvoll gezeigt, wie viele Mikroorganismen tatsächlich vorhanden sind. Zudem führten wir einen spannenden Versuch durch, bei dem wir unseren Daumen vor und nach dem Händewaschen auf das Vorhandensein von Mikroorganismen untersuchten. Die Ergebnisse waren beeindruckend und verdeutlichten die Bedeutung einer gründlichen Handreinigung.
Insgesamt hat uns dieses Projekt nicht nur viel über Bakterien beigebracht, sondern auch darüber, wie wichtig Hygiene für unsere Gesundheit ist. Wir freuen uns darauf, unser Wissen weiterzugeben und gemeinsam für eine saubere und gesunde Schulumgebung zu sorgen!